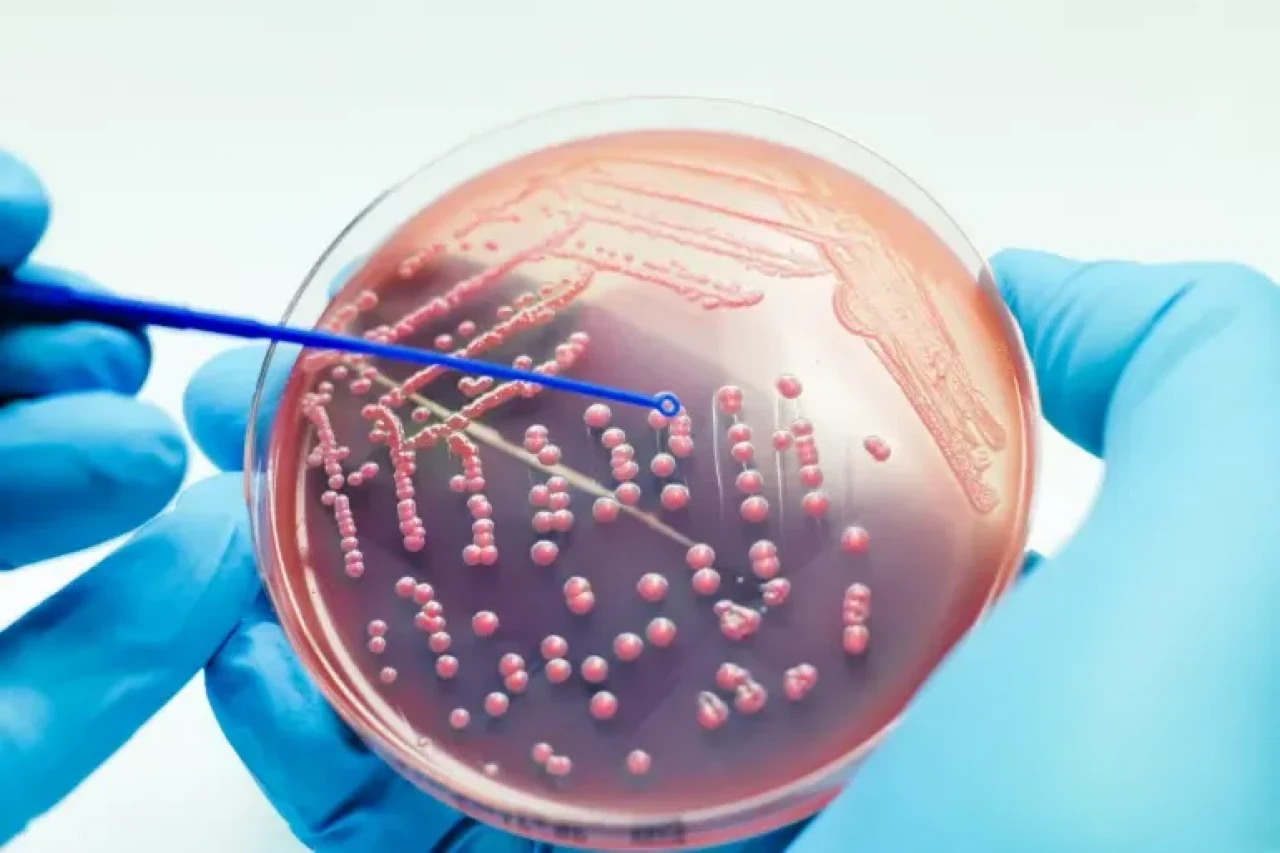
Yeni Maddeyle Bakterilerin %99.9’u yok ediliyor

Rus Bilim İnsanlarından Morötesi Işık Yayan Dezenfektan Madde: 40 Dakika Süren Etki
Rusya'da geliştirilen yeni bir kimyasal bileşik, 40 dakika boyunca morötesi (UV) ışık yayarak bakterilerin %99.9’unu öldürebiliyor. Bu yenilik, sağlık ve hijyen teknolojilerinde önemli bir dönüm noktası olabilir.
Ural Federal Üniversitesi'nden bilim insanları, itriyum fosfat ve özel seramik tozlarını kullanarak, X-ışınlarıyla aktive edilebilen ve uzun süreli morötesi ışık yayabilen bir madde geliştirdi. Söz konusu bileşik, özellikle sıvıların ve yüzeylerin dezenfeksiyonunda etkili sonuçlar verdi.
40 Dakikalık Parlama: Yeni Bir Rekor
Araştırma ekibi, bileşiğin X-ışını ile şarj edildikten sonra yaklaşık 40 dakika boyunca morötesi ışık yaymaya devam ettiğini gözlemledi. Bu süre, Çin'deki benzer çalışmalarda ulaşılan 15 dakikalık UV yayım süresine göre büyük bir ilerleme olarak değerlendiriliyor.
Bu uzun süreli UV yayımı sayesinde, özellikle hastane ortamlarında, tıbbi cihazlarda ve sterilizasyon gerektiren yüzeylerde kullanım potansiyeli taşıyor. Bilim insanları, bu maddenin aynı zamanda cıvalı ultraviyole lambaların yerine geçebileceğini belirtiyor.
Dezenfeksiyonda Yeni Dönem
Çalışmayı yöneten Prof. Dr. Yuliya Kuznetsova, maddenin potansiyelini şu sözlerle özetledi:
“Eğer bir implant, bu bileşikle kaplanırsa, X-ışını maruziyeti sonrası uzun süre bakterisiz bir yüzey sağlar. Üstelik bu etki, implant vücut içine yerleştirildikten sonra da devam edebilir.”
Bu yaklaşım, ameliyat sonrası enfeksiyon riskini azaltmak ve sterilizasyon ihtiyacını minimuma indirmek gibi kritik alanlarda önemli avantajlar sunabilir.
Daha Etkili Bir UV Spektrumu
Yeni bileşik tarafından yayılan morötesi ışık, yakın ve orta UV spektrumuna göre %70 daha etkili olarak değerlendiriliyor. Bu sayede, daha az enerjiyle daha yüksek dezenfeksiyon kapasitesine ulaşmak mümkün hâle geliyor.
Araştırmacılar, bu teknolojinin sadece sağlık sektöründe değil, gıda endüstrisi, su arıtma sistemleri ve laboratuvar ekipmanları gibi birçok alanda kullanılabileceğini belirtiyor.